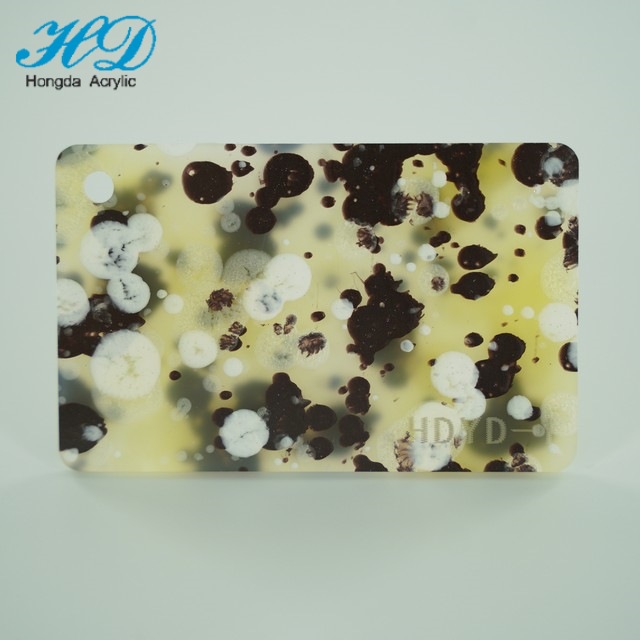
【厂家直销】源头工厂高品质亚克力雨珠纹小板PMMA有机玻璃板

1688工业品为您提供在线免费查询更多有机玻璃制品详细参数、实时报价、规格一览表。更多关于有机玻璃制品多少钱一千克/有机玻璃制品报价明细/有机玻璃制品规格型号价格表/有机玻璃制品批发市场价格/有机玻璃制品官方报价等咨询,尽在1688工业品。询底价>
为你找到亚克力板相关产品
【厂家直销】源头工厂高品质亚克力雨珠纹小板PMMA有机玻璃板
江西九江
在线询价

亚克力板长虹玻璃板条纹板石头纹板贝壳纹钻石纹板碎冰花细方格板
广东东莞
在线询价

厂家批发销售 亚克力广告灯饰 2mm黑白亚克力扩散板 可按尺寸加工
广东广州
在线询价

高透明亚克力板加工批发彩色UV印刷跨境摆件 展示盒 有机玻璃PS板

广东中山
在线询价

【源头工厂】高品质厂家直供亚克力半透葱粉PMMA有机玻璃板
江西九江
在线询价

【厂家直销】特殊亚克力木纹板 仿木纹装饰优质PMMA有机玻璃板
江西九江
在线询价

新涛亚克力高透明有机玻璃厚板尺寸切割T型桌腿20 30 40 50抛光
广东佛山
在线询价

跨境透明亚克力板有机玻璃板任意激光切割雕刻打孔个性化印刷
广东东莞
在线询价

展示盒防尘亚克力棒收藏跨境方形盒球类收纳盒有机玻璃透明球其他
浙江金华
在线询价

厂家【日销百吨】高清亚克力板PS板透明阻燃板厚度1-300MM加工
广东东莞
在线询价

【厂家直销】源头工厂亚克力双面平面振动珠光板PMMA有机玻璃板
江西九江
在线询价

水波纹透明亚克力玻璃画板diy涂鸦彩绘郁金香氛围感小夜灯摆件
浙江金华
在线询价
查看更多产品及报价
100+亚克力板相关产品等你解锁
AI找工业3000行家正在找货
AI找品,免费询价,源头正品,上1688工业品,全国的工业正品交易平台





